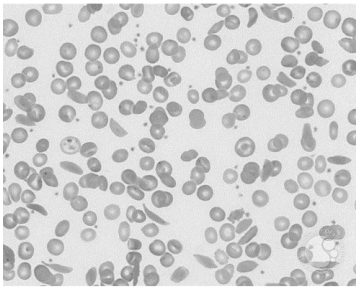
Enunciado 4791625-1

Uma criança de 1 ano de idade, moradora da zona rural de um
pequeno município distante da capital, e que não era
acompanhada por pediatra, é trazida para uma emergência com
febre, dor torácica intensa, icterícia e palidez.
Seus exames de laboratório mostravam:
- hemoglobina: 7,5 g/dL.
- leucócitos: 12.500/µL, com neutrofilia e desvio à esquerda.
- plaquetas: 250.000/µL.
- contagem de reticulócitos: 6%.
- LDH: 700 UI/µL.
- bilirrubinas totais: 4,5 mg/dL.
- bilirrubina indireta: 4 mg/dL.
Foi feito um esfregaço do sangue periférico, cujo resultado pode-se ver a seguir.

O diagnóstico de base mais provável para esse caso é
Seus exames de laboratório mostravam:
- hemoglobina: 7,5 g/dL.
- leucócitos: 12.500/µL, com neutrofilia e desvio à esquerda.
- plaquetas: 250.000/µL.
- contagem de reticulócitos: 6%.
- LDH: 700 UI/µL.
- bilirrubinas totais: 4,5 mg/dL.
- bilirrubina indireta: 4 mg/dL.
Foi feito um esfregaço do sangue periférico, cujo resultado pode-se ver a seguir.
O diagnóstico de base mais provável para esse caso é
Provas
Questão presente nas seguintes provas